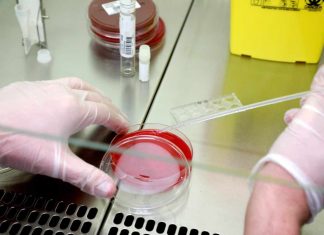
Étude américaine : La chloroquine ne montre aucun signe d’efficacité contre le Covid-19 Étude américaine : La chloroquine ne montre aucun signe d'efficacité contre le Covid-19

Actualités coronavirus : 1 500 cas confirmés dans les armées françaises
Le ministère des Armées compte 1 500 cas confirmés de coronavirus parmi ses personnels, dont 1 081 marins membres d'équipage du porte-avions Charles de...
Coronavirus France EN DIRECT : suivez l’évolution de la situation Mercredi 22 avril
Le Royaume-Uni fait face au "pic" de l'épidémie. Le pays a enregistré 759 nouveaux décès à l'hôpital de patients atteints par le nouveau coronavirus,...
Actualités coronavirus : «Le virus va nous accompagner pendant « longtemps »
Le monde est loin d’en avoir fini avec le nouveau coronavirus, qui a fait plus de 177 800 morts, a averti le directeur général...
Étude américaine : La chloroquine ne montre aucun signe d’efficacité contre le Covid-19
Une étude américaine n'ayant pas encore été acceptée pour publication dans une revue médicale montre que l'hydroxychloroquine n'apporterait pas d'amélioration et présenterait un risque...
Actualités coronavirus : Les restaurants, bars et cafés pourraient rouvrir à partir du 15...
Le 11 mai, l’activité devrait progressivement se remettre en marche : les écoles, les coiffeurs, les commerces devraient rouvrir, dans le respect de nouvelles...
Coronavirus France EN DIRECT : Les lieux de culte ne rouvriront pas en mai
Les lieux de culte ne rouvriront pas le 11 mai, a indiqué mardi soir Emmanuel Macron aux responsables des cultes, en prévoyant une évaluation...
Actualités coronavirus : plus de 10 millions de salariés au chômage partiel
Plus de 10 millions de salariés, soit plus d’un salarié du secteur privé sur deux, sont concernés par le chômage partiel, un chiffre «...
Actualités coronavirus : 531 décès supplémentaires en 24 heures en France
Dans son point hebdomadaire depuis le ministère de la Santé, le Directeur général de la Santé, Jérôme Salomon, a souligné que 531 personnes étaient...
Coronavirus France EN DIRECT : Île-de-France, 191 morts en 24h à l’hôpital
191 personnes sont mortes du coronavirus dans les hôpitaux d'Île-de-France au cours des dernières 24 heures, selon les informations communiquées par l'Agence régionale de...
Actualités coronavirus : Plus de 20.000 morts en France
Lundi soir, le Directeur général de la santé Jérôme Salomon a annoncé que la France a franchi le cap des 20.000 morts du coronavirus,...